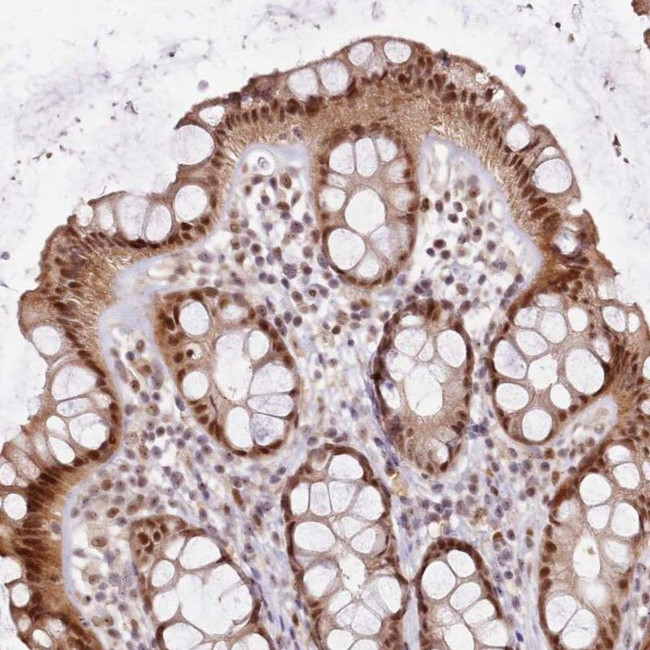
LGALSL Antibody in Immunohistochemistry (IHC)

Search
Invitrogen
LGALSL Polyclonal Antibody
{{$productOrderCtrl.translations['antibody.pdp.commerceCard.promotion.promotions']}}
{{$productOrderCtrl.translations['antibody.pdp.commerceCard.promotion.viewpromo']}}
{{$productOrderCtrl.translations['antibody.pdp.commerceCard.promotion.promocode']}}: {{promo.promoCode}} {{promo.promoTitle}} {{promo.promoDescription}}. {{$productOrderCtrl.translations['antibody.pdp.commerceCard.promotion.learnmore']}}
Additional Information:
{{banner.description}}
产品信息
PA5-61143
产品规格
宿主/亚型
Rabbit
/ IgG
分类
Polyclonal
类型
Antibody
抗原
Recombinant protein corresponding to Human LGALSL
偶联物
形式
Liquid
浓度
0.05 mg/mL
规格
5 µg
保存条件
Store at 4°C short term. For long term storage, store at -20°C, avoiding freeze/thaw cycles.
运输条件
Wet ice
RRID
产品详细信息
Immunogen sequence: LNNSLSSPVQ ADVYFPRLIV PFCGHIKGGM RPGKKVLVMG IVDLNPESFA ISLTCGDSED PPADVAIELK
Highest antigen sequence identity to the following orthologs: Mouse - 99%, Rat - 99%.
靶标信息
Does not bind lactose, and may not bind carbohydrates.
仅用于科研。不用于诊断过程。未经明确授权不得转售。
篇参考文献 (0)
您是否在文献中引用过该产品?请点击下方按钮邮件告知我们。